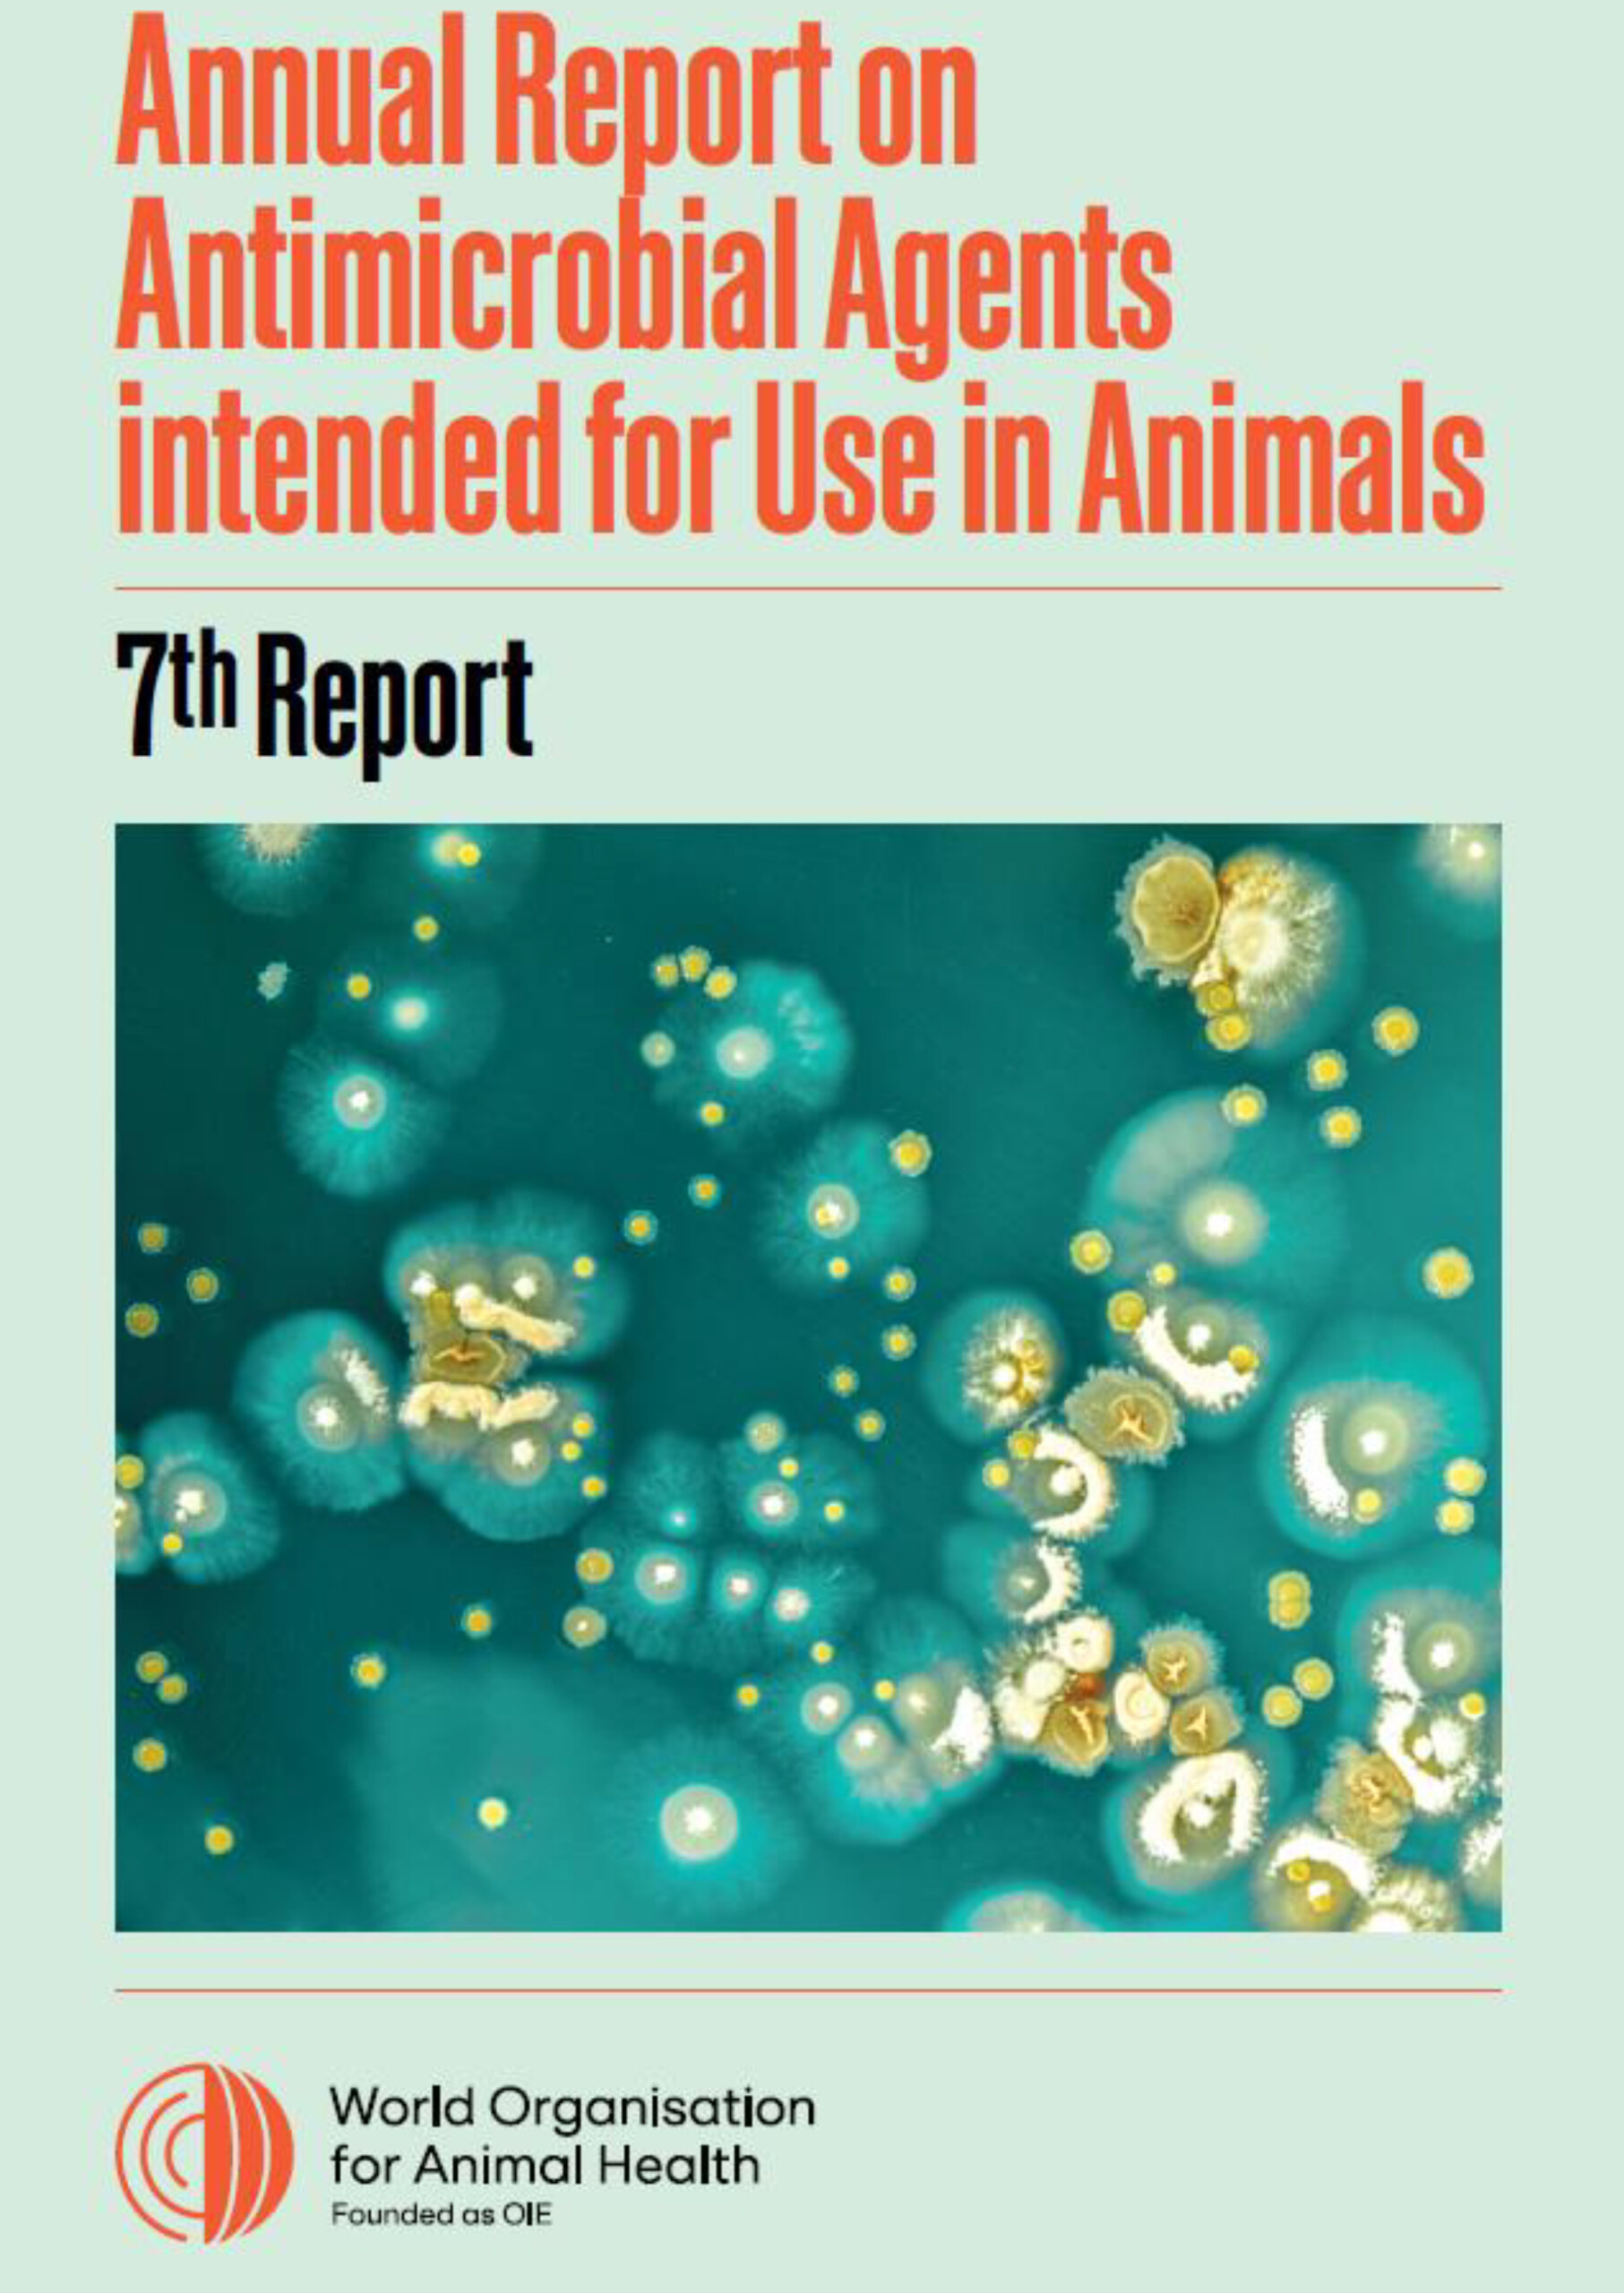

Antimicrobial resistance is one of the greatest global health challenges of our time, becoming a leading cause of death globally. It is a growing threat to animal and human health, as well as livelihoods and food security worldwide. Addressing AMR requires a holistic and multi-sectoral approach referred to as a One Health approach.
Commemorated from 18-24 November every year, World AMR Awareness Week (WAAW), previously known as World Antimicrobial Awareness Week, is a global campaign which aims to raise awareness and encourage action among One Health stakeholders to tackle the emergence and spread of drug-resistant pathogens. Fighting AMR is a global endeavour and requires collective action from all sectors of society. This is why this year’s theme calls for collaboration across sectors to preserve the efficacy of these critical medicines. With the concept of cross-sectoral collaboration in mind, the theme for this year’s WAAW week is:
World AMR Awareness Week 2023 builds on last year’s theme, ‘Preventing Antimicrobial Resistance Together’, encouraging stakeholders around the world to collaborate across sectors to preserve the medicines that help save lives.
This year’s WAAW theme aims to encourage stakeholders, including policymakers, health care providers, and the general public to recognise that everyone can help tackle antimicrobial resistance.
The overall slogan for raising awareness on AMR during WAAW remains the same as in previous years – Antimicrobials: Handle with care.
WOAH and its partners have prepared a number of resources to support awareness campaigns. These include: posters, stakeholder leaflets, media engagement leaflet, farmer’s infographic, social media squares and GIFs, web banners and video. The Quadripartite group of partner organisations (FAO, UNEP, WHO, WOAH) has also developed many materials which are shared in a Trello Board.